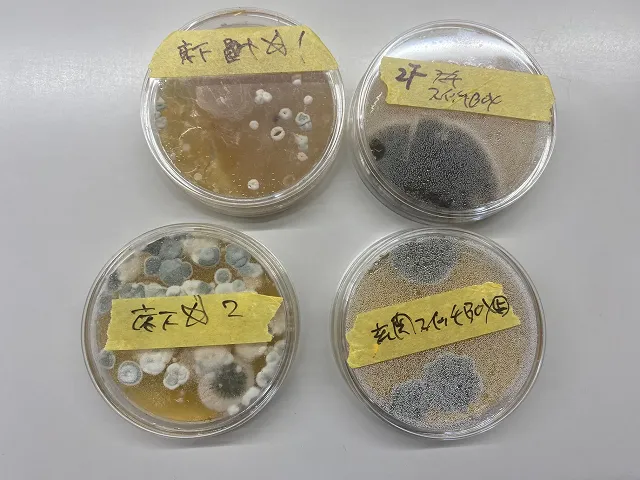

【関東のカビ完全対策ガイド】原因調査・真菌検査で再発を防ぐ!MIST工法®カビバスターズ東京が徹底サポート✨
2025/11/27
【関東のカビ完全対策ガイド】原因調査・真菌検査で再発を防ぐ!MIST工法®カビバスターズ東京が徹底サポート✨
東京・神奈川・千葉・埼玉・群馬・栃木・茨城のカビ悩みを科学的に調査!真菌検査・含水率診断・ファイバースコープ調査で原因を“見える化”します🕵️♂️🌱
こんにちは😊
MIST工法®カビバスターズ東京です!
「最近お部屋がカビ臭い気がする…」「何度掃除しても同じ場所に黒いモヤモヤが😢」そんなお悩みはありませんか? 関東地方の住宅は気密性が高く、湿気がこもりやすいため、カビが発生しやすい環境が整ってしまっています。実際に、東京・神奈川・千葉・埼玉・群馬・栃木・茨城 から毎日のようにカビに関するご相談をいただいています。
私たちが大切にしているのは、「表面的な掃除」ではなく “カビが生えてしまった原因を科学的に突き止めること” です✨
一般社団法人微生物対策協会と連携し、室内にどんなカビ菌が存在するのかを調べる 真菌(カビ菌)検査 を行い、どの種類がどこに発生しているかを“見える化”します。さらに、壁や床などの湿気状態を知る 含水率検査、壁内部の状態を確認する ファイバースコープ調査📷、空気の流れや負圧の有無を確認する 風量計による負圧検査🌬 など、多角的な調査で原因をしっかり追究します。
現代の住宅はとても気密性が高いため、原因を改善しないまま放置すると、どれだけキレイにしてもカビが再発してしまうことが多いんです💦
「もう自分ではどうにもできない…」
「家族の健康が心配😢」
そんな時こそ、MIST工法®カビバスターズ東京 にぜひご相談ください。関東エリアのカビトラブルは私たちがしっかりサポートします💪🌱
まずは 真菌検査で現状を正しく把握すること をおすすめします。
あなたの大切な住まいを、カビから守るお手伝いをさせてくださいね✨
目次
【はじめに】関東でカビが増えやすい理由とは?
関東の住宅は“カビが育ちやすい環境”がそろっている!?気候・構造・生活スタイルから徹底解説🌧🏠✨
■ 関東の気候と住宅事情
関東地方は「比較的温暖で湿度が高い」という特徴があり、実はカビがとても育ちやすい地域です。梅雨時期はもちろん、夏は高温多湿、冬は結露が多く発生し、年間を通してカビが繁殖する条件が整いやすくなっています。例えば、東京・神奈川・千葉などの沿岸エリアは湿気が溜まりやすく、外気温と室内温度の差が大きい冬場には窓や壁に結露がつきやすい環境になります。また、関東の住宅は高気密・高断熱化が進んでおり、夏の冷房・冬の暖房によって室内外の温度差が生まれ、壁内部の湿度が高まることも珍しくありません。
さらに、マンション・戸建て問わず、近年は気密性を重視した住宅が増えているため、空気の逃げ道が少なく、湿気がこもりやすくなっています。本来であれば換気システムが適切に機能すべきですが、24時間換気の不具合やフィルターの汚れ、間取りの構造によって空気が循環しにくいケースも多く見られます。湿気は“目に見えない場所”に滞留しやすく、壁紙の裏、床下、クローゼット内部などでカビが広がることもあります。関東の住宅事情は便利で快適な反面、カビが発生しやすい要素が重なりやすく、住む人が気付かないうちにカビが繁殖してしまうことも多いのです。こうした背景から、関東地方では「気づいたらカビが増えていた…」というご相談が非常に多く寄せられています。
■ 東京・神奈川・千葉・埼玉・茨城・栃木・群馬で相談が増えるワケ
関東全域からカビに関するお問い合わせが増えている理由は、単純に「湿気が多いから」だけではありません。都市部と郊外でカビの発生理由が微妙に異なる点も大きなポイントです。
まず東京・神奈川・千葉・埼玉などの都市部は、マンションや高気密住宅が多く、夏は湿度がこもり、冬は結露が増加する傾向があります。特にマンションの角部屋や北側の寝室は温度差が大きく、壁内部に結露が生じやすい環境です。また共働き家庭が多いため、長時間締め切った室内で湿度が滞留し、カビが繁殖しやすい状態が続きやすくなります。
一方で茨城・栃木・群馬などの北関東エリアでは、冬の寒さが強く、窓・壁・床下の結露が多く発生します。さらに戸建て住宅が多いため、床下の湿気、土台まわりの結露、外気との温度差による壁内部の湿度トラブルなどが発生しやすい傾向があります。
また近年、関東地方では気候変動の影響もあり、秋雨時期の長雨、ゲリラ豪雨、台風時の湿度上昇などが原因でカビの相談が急増しています。地域ごとの気候差と住宅事情が組み合わさることで、「どこに住んでいてもカビが発生しやすい」という状況が生まれているのです。だからこそ、関東エリアではカビへの早期の気づきと、専門家による原因調査がとても重要になります。
■ カビを“掃除だけで解決しない”理由
「カビを掃除したのにまたすぐ生えてくる…」
この悩みは関東のお客様から非常に多く寄せられます。実は、カビは“目に見える表面部分”だけを掃除してもほとんど解決しません。原因が残っている限り、必ずと言っていいほど再発してしまうのです。
その理由として大きいのが、カビの発生要因が表面ではなく 壁の中・床下・断熱材の裏側など、目に見えない場所に潜んでいること です。湿気が内部に入り込んでいる場合、表面をどれだけきれいにしても内部の湿気が残っている限り、再びカビが繁殖してしまいます。
さらに、換気不良による負圧状態(室内の空気が外に逃げず、湿気が吸い込まれる現象) が起きていると、外部や隙間から湿気が室内へ引き込まれ、カビの原因を助長します。これを特定するには、風量計による負圧検査が欠かせません。
また、関東の住宅では壁内部の湿気が高まりやすく、これを判断するには含水率検査が重要です。表面のカビを落としても、壁の裏で湿気が45%以上ある状態が続けば、カビは何度でも発生します。
つまり、掃除は“結果”に対する対処であり、原因に対する対処ではない のです。
だからこそ関東地方では、真菌検査・含水率検査・ファイバースコープなどによる“根本原因の特定”が再発防止のカギとなります。
カビはどうやって発生するの?基本メカニズムをやさしく解説🌱
カビは“気づかないうちに育つ生き物”!?温度・湿度・住宅構造から分かる発生メカニズムをやさしく解説✨
■ カビが好む温度・湿度・栄養
カビはとても生命力が強く、「温度・湿度・栄養」がそろうと一気に繁殖する特徴があります。特に関東地方では、この3つの条件が揃いやすいため、家のあらゆる場所でカビが発生しやすくなっています。
まず温度ですが、カビが最も活発に繁殖するのは 20〜30℃前後。これはまさに私たちが普通に生活している室温とほぼ同じです。冷暖房を使う現代の住宅では一年を通してこの温度帯になりやすく、季節に関わらずカビが増えやすい環境ができてしまいます。
湿度は 60%を超えると一気にカビの活動が活発化 し、梅雨〜夏はもちろん、冬でも加湿器の使い過ぎや結露によって湿度が高くなりがちです。洗濯物の部屋干し、浴室の湿気、料理の蒸気など、日常の生活行動も湿度を高める原因になります。
また、カビにとっての栄養源は特別なものではなく、家の中に普通に存在するものばかりです。
ホコリ・繊維くず・皮脂・石けんカス・木材の成分・紙・壁紙の糊…こうした“ちょっとした汚れや素材”がカビのエサになります。つまり、「掃除しているつもりでも、カビのエサは常に存在している」のが現実です。
このように、カビは「温度・湿度・栄養」という3つの条件がそろうと24〜48時間ほどで一気に増殖する生き物です。特に関東地方は湿度が高く、気温も安定しているため、カビが育つ条件がそろいやすい地域と言えます。だからこそ、カビの予防や原因特定が非常に重要になってくるのです。
■ 気密性の高い現代住宅の落とし穴
現代の住宅は“高気密・高断熱”が当たり前になりました。冬は暖かく、夏は涼しく、とても快適に過ごせる一方で、実はこの構造がカビの発生リスクを大きく高めていることをご存じでしょうか?
気密性が高くなると、外からの空気が入りにくく、室内の湿気や水蒸気がこもりやすくなります。換気システムが正常に働いていれば問題ありませんが、24時間換気のフィルターが詰まっていたり、空気の通り道がふさがれていたりすると、湿気が室内に溜まり続けてしまいます。これがカビの絶好の繁殖環境となるのです。
さらに深刻なのが、“壁の中や床下など、見えない場所に湿気が溜まる”という現象です。現代住宅は断熱材が厚いため、外気との温度差が生まれやすく、壁内部で結露が起きやすい構造になっています。表面はきれいでも、壁の裏ではカビが広範囲に広がっているケースも少なくありません。
また、気密性の高い住宅では「負圧」が起きやすく、外から湿った空気を壁の隙間へ引き込んでしまうことがあります。これにより、壁内部の湿気が増え、含水率が上昇し、気が付かないうちにカビが発生してしまうのです。この状態を見極めるには専門の風量計や含水率計、さらにはファイバースコープでの壁内部確認が必要になります。
このように、高気密住宅は快適さと引き換えに“湿気トラブルを溜めやすい構造”になっているため、原因調査を怠ると何度でもカビが再発する危険性があります。掃除ではなく、正しい原因追究が必要になる理由がここにあります。
■ 「におう」「しみがある」こんなサインはカビの可能性!
カビは突然ドンッと現れるのではなく、「あれ?なんか変だな?」という小さなサインから始まります。これに気づけるかどうかで、その後のカビの広がりが大きく変わります。
まず分かりやすいのが “におい” です。
・カビ臭い
・湿っぽい
・古い雑巾のようなにおい
・エアコンからのにおい
これらは、目に見えない場所でカビが繁殖している可能性が非常に高いです。においはカビが生きて活動している証拠で、壁裏や床下にまで広がっていることも少なくありません。
次に注意すべきなのが “しみ・変色”。
壁紙の一部だけ茶色くなっている、黒い点々が増えていく、天井に薄い輪じみがある…これらは内部結露や漏水が原因でカビが繁殖している可能性があります。表面を拭いても再び出てくるようなら、ほぼ確実に内部の湿気トラブルが疑われます。
さらに見落としがちなのが “なんとなく空気が重い” “部屋がじめっとする” という感覚的なサインです。湿度が高い・換気がうまくいっていない・負圧になっているなど、カビが育ちやすい環境が整っている証拠です。
もしこのようなサインを感じた場合は、早い段階での真菌検査・含水率検査・ファイバースコープによる内部チェックがとても重要です。カビは初期対応が早いほど再発率を下げられるため、「あれ?」と思ったら迷わず原因調査を行うことをおすすめします。
放置は危険!カビがもたらす健康リスクと家へのダメージ😢
「見えないから大丈夫」は大きな誤解!カビが体と住まいに与える深刻なダメージを徹底解説😢🏠
■ アレルギー・ぜんそく・咳などの健康リスク
カビを放置すると、私たちの体にさまざまな悪影響が出る可能性があります。特に関東地方は湿度が高く、住宅が密閉化されているため、空気中にカビの胞子が舞いやすく、知らず知らずのうちに体に吸い込んでしまうケースが多く見られます。カビは“ただの汚れ”ではなく、れっきとした微生物です。種類によっては強いアレルギー反応を引き起こすものもあり、健康被害を軽視できません。
最も多いのが アレルギー性鼻炎・咳・くしゃみ・喉の違和感 などの症状です。カビの胞子は空気中に漂い、呼吸とともに吸い込まれることで気道を刺激します。さらに長期間吸い込み続けると、気管支へ影響が及び、ぜんそくの悪化や慢性的な咳 が続くケースもあります。
また、関東地方で特に報告されるのが「夏型過敏性肺炎」という疾患です。これはカビを吸い込むことで肺に炎症が起こり、発熱・息苦しさ・全身の倦怠感などが現れるもので、症状が重い場合は入院が必要になることもあります。エアコン内部のカビや、壁紙裏で増殖したカビが原因となることが多く、一般の方は気づきにくいのが特徴です。
「ただの湿気だから大丈夫」「少しカビがあるだけで病気になるの?」と思う方もいますが、カビは空気に乗って体内に入り、免疫に影響を与えることがあるため注意が必要です。特に、関東のような湿度が高い地域はカビとの接触機会が増えるため、早めに原因調査を行い、健康被害を防ぐことが重要です。
■ 小さな子ども・高齢者・ペットのリスク
カビによる健康リスクは、すべての人が同じように受けるわけではありません。実は 小さな子ども・高齢者・ペット は特にカビの影響を受けやすいと言われています。これは、免疫力や身体機能の違いによるもので、関東地方から寄せられる相談でも「子どもが急に咳き込むようになった」「ペットが体をかゆがるようになった」という声が多く聞かれます。
まず小さな子どもは、免疫機能がまだ発展段階にあり、大人よりも空気中の刺激を受けやすい状態です。カビの胞子が多い室内で過ごすと、アレルギー反応を起こしやすく、鼻水、咳、蕁麻疹、ぜんそく症状などが悪化することがあります。また、寝室や子ども部屋は窓を閉めている時間が長く、エアコン・加湿器を使うことで湿気がこもりやすく、カビのリスクが高まりやすい空間です。
高齢者の方は免疫力が下がっていることに加え、呼吸器の働きが弱くなっているため、カビの影響を受けやすい傾向があります。慢性咳や呼吸困難が起きやすく、既存の病気を悪化させてしまうこともあります。また、関東の寒暖差が激しい冬は結露が増え、気が付かないうちにカビが広がってしまうケースも多く見られます。
ペットの場合、床の近くで生活しているため、カビの胞子を吸い込みやすい環境にあります。湿気が溜まりやすい床付近は、カビが一番繁殖しやすい場所でもあり、皮膚炎・アレルギー・呼吸器の不調などにつながることがあります。犬や猫は自分では不調を訴えられないため、飼い主が早めに気付いて環境を整える必要があります。
このように、カビは特定の人に特に大きな影響を与えるため、家族に小さな子どもや高齢者、ペットがいるご家庭はとくに早い段階でのカビ対策や原因調査が大切です。
■ 壁紙・木材・断熱材への広がり
カビを放置すると、表面だけではなく“内部”へとどんどん広がっていきます。最初は壁紙の黒い点や浴室の汚れ程度だったものが、時間が経つにつれて 木材・壁紙の裏・断熱材・床下 へと浸透し、住まいの構造そのものに影響を及ぼすことがあります。
例えば壁紙の裏側は、湿気が溜まりやすい“カビの温床”になりやすい場所です。壁紙が少し浮いている、変色している、触ると冷たい——これらのサインは、内部に湿気が入り込み、カビが繁殖している可能性があります。表面を拭いてもすぐにまた黒ずむ場合は、その裏でカビが広がっていることがほぼ確実です。
さらに深刻なのが木材への影響です。木材は湿気を吸いやすく、含水率が高くなるとカビが定着しやすくなります。木材内部でカビが繁殖すると、強度が低下したり、腐朽菌が発生しやすくなったりするため、建物の耐久性が落ちる可能性があります。また、断熱材は湿気を含むと性能が低下し、壁内部の温度差が大きくなることで結露が増え、さらにカビが広がりやすくなる「負のループ」が起きます。
現代の住宅では、内部構造が複雑で湿気が抜けにくいため、内部のカビを放置すると広範囲に拡大してしまうことが珍しくありません。壁の内部を確認するには、表面からは見えないため、ファイバースコープなどの専門機器を使った調査が必要になります。
住まいの「表面だけで判断しない」ということが、カビ対策において非常に重要なのです。
■ 資産価値を下げてしまうケース
カビは「見た目が悪い」「においが気になる」という問題だけではなく、家の資産価値を大きく下げてしまう原因 になることがあります。特に関東地方では住宅価格が高く、マンション・戸建てともに資産として所有されている方も多いため、カビによる価値低下は深刻な問題です。
まず、カビが壁紙・床・天井に広がると、見た目の印象が大きく悪化します。内見時にカビ臭さがある物件は避けられやすく、売却の査定額が下がることも珍しくありません。また、隠れカビが内部に広がっていると、リフォーム費用が高額になり、買い手が敬遠する要因になります。
さらに木材がカビによりダメージを受けると、建物の強度や耐久性に影響する場合があり、「構造に問題がある物件」と判断されることもあります。また、断熱材が湿気を含み性能が低下すると、光熱費が上がり、生活コストの面でもマイナス評価につながります。
マンションでは管理組合から指摘されるケースもあり、貸し出している場合は入居者からのクレームや退去へつながる可能性もあります。「住みづらい」「においが気になる」「健康不安がある」といった理由で入居率が低下すれば、家賃収入にも影響が出てしまいます。
このように、カビを放置することは見えない部分で資産価値に直結する問題を引き起こします。早期に真菌検査・含水率検査を行い、原因を特定して対処することが、資産を守るためにも非常に重要なのです。
【関東版】カビが特に発生しやすい場所ベスト7
「その場所、危険かも…!」関東の家でカビが特に増えやすい“見逃しがちなポイント”を徹底解説✨
■ お風呂場
お風呂場は、家の中で最もカビが発生しやすい場所と言っても過言ではありません。特に関東地方は湿度が高いため、入浴後の湿気がこもりやすく、カビにとって理想的な環境が整いやすいのです。お風呂場は「水分・温度・栄養」というカビの繁殖条件が完璧にそろうため、一度発生すると短期間で一気に広がることがあります。シャンプーや石けんカス、皮脂汚れはカビの栄養となり、湿った空間で放置すれば、黒カビや赤カビがタイルの目地やゴムパッキンに定着してしまいます。
また、浴室乾燥機や換気扇を設置していても、「使い方が正しくない」「運転時間が足りない」ことで湿度が十分に下がらず、カビが残るケースが多く見られます。特に冬場は温度差から浴室内の結露が増え、さらにカビが発生しやすくなります。扉の下部、排水口まわり、棚の裏側などは見えにくく、気づくと広がっていることも。さらに浴室のカビは隣接する洗面所や脱衣所へも移りやすいため、早めの対策が欠かせません。お風呂場のカビは“住まい全体のカビリスクを広げる根源”にもなるため、特に注意が必要です。
■ エアコン内部
エアコン内部は、実はカビが大量に発生しやすい“隠れスポット”の代表格です。関東地方では夏の冷房・冬の暖房の使用頻度が高く、エアコン内部に温度差が生まれやすいため、内部で結露が発生しやすくなります。結露によって濡れた状態になったファン部分やフィンにカビ菌が付着し、そのまま湿気の多い時期を迎えると、一気に繁殖してしまうことがあります。
問題なのは、このカビが“空気と一緒に部屋中に撒き散らされる”という点です。エアコンをつけた瞬間に「なんだかカビ臭い」「ホコリっぽい空気が出ている気がする」という場合は、内部でカビが広がっている可能性がとても高いです。特に寝室のエアコンにカビがあると、就寝時にカビを吸い込むことになり、咳・鼻水・目のかゆみ・アレルギーの悪化などに繋がる恐れがあります。
また、エアコン内部のカビは表面の掃除だけでは取り除けないことが多く、内部の奥の奥、熱交換器やドレンパンにまで広がっている場合もあります。関東の住宅は気密性が高く、エアコンの使用時間も長いため、知らないうちに部屋全体の空気質に影響を与えてしまうケースが多発しています。エアコンの異臭は“家全体のカビリスクのサイン”でもあるため、早めのチェックと原因調査が必要です。
■ 北側の寝室
北側の部屋は一年を通して日当たりが弱く、風通しが悪くなりやすいため、カビが特に発生しやすい場所としてよく知られています。関東地方の冬は気温が下がりやすく、北側の壁や窓が冷やされることで結露が発生し、その水分が壁紙や下地の木材に吸収されてしまいます。これがカビの繁殖につながる大きな原因です。
寝室は長時間閉め切ることが多く、人の呼吸によって湿度が上がりやすい空間でもあります。特に冬場に加湿器を使用すると湿度がさらに高まり、壁紙の裏や家具の裏でカビが育ちやすくなります。布団やマットレスの裏側にカビが生えてしまうケースも多く、朝起きたときに部屋が“なんとなくじめっとしている”と感じたら要注意です。
北側の部屋は気温差による内部結露が起こりやすいため、壁内部でカビが広がってしまうこともあります。表面に薄いシミや変色が出ている場合、内部ではすでにカビが進行している可能性があります。北側の寝室のカビは「掃除しても戻ってくる」と相談されることが多く、根本原因の特定には含水率検査やファイバースコープによる内部チェックが欠かせません。
家族が長時間過ごす寝室だからこそ、少しの変化に気づき、早い対応がとても大切です。
■ クローゼット
クローゼットは、家の中でも意外とカビが発生しやすい場所です。密閉空間で換気がほとんどされず、衣類が湿気を吸いやすいため、カビにとって理想的な繁殖環境になりやすいのです。関東地方の気候は湿度が高く、特に梅雨〜夏の時期には、クローゼット内部の湿度が70〜80%に達することも珍しくありません。
クローゼットにぎゅうぎゅうに衣服を詰め込むと空気が流れなくなり、湿気がこもりやすくなります。湿気を含んだ衣類が密着していると、そこからカビが繁殖し、白カビや黒カビが衣服やバッグに広がってしまうことも。特に革製品や紙製品はカビの影響を受けやすく、一度カビが生えると完全に取り除くのが難しくなります。
また、クローゼットは外壁側に配置されていることが多く、壁内部で結露が起きやすい構造になっています。壁紙の裏側でカビが繁殖していた…というケースは珍しくありません。クローゼットを開けた瞬間に「むわっと湿気を感じる」「カビ臭い」と思ったら、内部や壁の裏側のカビを疑う必要があります。
さらに、クローゼット下部の床は空気が動きにくく、湿気が溜まりやすい場所です。ダンボール箱を長期間置いたままにすると、その下でカビが広がることもあります。関東地方でクローゼットのカビ相談が多い理由は、湿度・気密性・生活スタイルの影響が重なっているからです。
■ 洗面所まわり
洗面所は日常生活で頻繁に水を使う場所であり、湿度が上がりやすく、カビが発生しやすい環境が整っています。歯磨き・手洗い・洗顔・ドライヤーの使用など、日々の生活によって空気中に水蒸気が放出され、壁や天井に湿気が付着しやすくなります。特に関東の住宅は気密性が高いため、湿気がこもりやすく、洗面台の下や裏側、洗濯機の周囲などにカビが広がるケースが多く見られます。
また、洗面所はお風呂場と隣接していることが多く、浴室からの湿気が流れ込むことで湿度がさらに上昇します。換気扇が1つしかなく、浴室と洗面所を同時に換気しきれない間取りも多く、湿気がたまりやすいのです。床材がクッションフロアなどの場合、水滴が床材と下地の間に入り込み、内部でカビが広がるケースもあります。
洗面台の下は特に要注意で、水漏れに気づかず放置すると、木材や下地が湿気を吸収してカビが繁殖します。扉を開けるとカビ臭がする、物を取り出したときに湿っている感じがする、そんなときは内部のカビが進行している可能性があります。
洗面所のカビは“家全体に広がる前兆”であることも多いため、早めの調査が重要です。
■ 玄関・下駄箱
玄関は外気と接する場所で、温度差が大きく結露が発生しやすいため、カビが生えやすいスポットの一つです。特に靴についた湿気や泥は、下駄箱の中でカビの栄養源となり、放置すると内部で一気に繁殖してしまいます。雨の日に濡れた靴をそのまま下駄箱に入れると、湿気が閉じ込められ、白カビ・黒カビが靴全体に広がることも珍しくありません。
また、関東の気候は季節の寒暖差が激しいため、玄関扉付近で結露が発生しやすく、壁紙や靴箱の裏側にカビが広がるケースが多発しています。玄関は換気がしづらく、湿気が滞留しやすい場所でもあります。特にマンションでは玄関周りが密閉空間になりがちで、湿度が上がるとカビ臭さが増してくることがあります。
また、靴箱の棚板に使用されている木材は湿気を吸いやすく、含水率が高くなるとカビが木の内部にまで侵入することがあります。靴だけでなく、棚板そのものに広がってしまうと、カビが取れにくく、においの原因にもなってしまいます。玄関のカビは家の第一印象を下げるだけでなく、室内にカビ胞子を持ち込む要因にもなるため、見逃せない問題です。
■ 家具裏や壁紙の裏側
家具裏や壁紙の裏側は、カビが最も発生しやすく、発見が遅れやすい“隠れスポット”です。特に関東地方の住宅は高気密構造で、空気の流れが悪いと壁に湿気がこもりやすく、家具が密着している部分は風が通らないため、カビの温床になりやすいのです。
家具を壁にぴったりくっつけて置くと、空気がまったく流れず、湿気が逃げない状態になります。関東は湿度が高いため、家具裏の壁紙は湿気を吸収し、気づかないうちに内部でカビが広がっていきます。冷たい北側の壁はとくに結露しやすく、家具があることで乾燥しにくくなるため、さらにカビが広がりやすい環境になります。
壁紙の裏側にカビが発生している場合、表面の黒ずみやシミだけでは判断できないことも多く、内部でどれほど広がっているかはファイバースコープで確認する必要があります。含水率が高い状態が続くと、壁紙を剥がすと一面に黒カビが広がっている…ということもあります。
また、家具裏のカビは衣類・本・家電などにも影響しやすく、においの原因にもなります。特にクローゼットや本棚、タンスの裏は要注意で、風通しが悪いと内部の湿気が逃げず、カビが長期間繁殖し続ける環境になります。
家具を少し壁から離す、空気の通り道を作るなど小さな工夫でカビ予防ができますが、すでににおいや黒ずみが出ている場合は内部のカビが進行している可能性があり、原因調査が必要です。
自分でやっても再発する理由💦
「なんでまたすぐ生えるの…?」掃除してもカビが再発する“本当の理由”をやさしく解説します🌱🌀
■ 表面だけ取れる「掃除の限界」
「しっかり掃除したのに、また同じ場所にカビが…!」
これは関東地域のお客様から最も多く寄せられるお悩みのひとつです。実は、家庭での掃除は“カビの表面部分”しか取り除けないことがほとんどで、再発を完全に防ぐことは非常に難しいのです。
カビは壁紙や木材などの素材に深く入り込む特徴があり、表面に見えている黒い点々や白いモヤモヤは、実は“ほんの一部”。本体である菌糸(根っこ)は素材の内部に広がっていることが多く、表面をこすって取ったように見えても、内部では生きたカビが温存されている可能性が高いのです。
さらに、市販のカビ取り剤は漂白力で表面を白く見せる効果がありますが、これは「カビが取れたように見える」だけで、内部に残った菌糸を完全に無力化できないことがあります。漂白されて元に戻ったように見えても、数日〜数週間後に同じ場所からカビが再発するのはこのためです。
また、強くこすり過ぎる掃除も逆効果になることがあります。カビの胞子が空気中に飛散し、周囲の壁や天井に付着することで、かえってカビの増殖範囲を広げてしまうことも。知らない間に“掃除が原因”でカビが家中に広がっていた…という例は少なくありません。
カビを本当に止めるには、「見えている部分」ではなく「見えていない原因」にアプローチすることが必要です。表面掃除だけで解決しない理由は、まさに“内部に残る菌糸”という大きな壁があるからなのです。
■ 目に見えない“壁の中”の湿気問題
カビの再発で最も厄介なのが、壁の中・床下・天井裏などの“見えない部分の湿気” です。関東の住宅は高気密で、室内外の温度差による結露が起きやすい構造になっているため、壁内部に湿気が入り込みやすく、そこがカビの温床となるケースが非常に多いのです。
壁紙を触ると冷たい、表面にシミがある、なんとなく湿っぽい——これらは内部に湿気が溜まっているサインです。しかし、内部の湿度は目で見ることができないため、表面だけを掃除しても根本の湿気は残り、結果としてカビが何度でも再発してしまいます。
さらに、内部の木材や断熱材は湿気を吸いやすい素材で、一度含水率が高い状態になると長時間乾かず、カビが育ちやすくなります。例えば含水率が20%を超えると木材内部でカビや腐朽が始まると言われており、これを一般の掃除で改善することはほぼ不可能です。
壁の中は外気との温度差が一番大きくなる場所でもあり、冬は内部結露が多発しやすく、夏は湿気が抜けにくくなるため、一年中カビのリスクが潜んでいます。こうした“隠れ湿気”を特定するには、含水率計やファイバースコープによる調査が必要になります。
掃除してもカビが繰り返し発生するのは、表面ではなく「壁の中」という見えない部分に本当の原因が残っているためなのです。
■ 換気不良と負圧の関係
換気が十分にできていないと、家の中の湿気が外へ逃げず、カビが発生しやすい環境が続いてしまいます。関東地方は高気密住宅が多く、気密性が高いほど換気不足になりやすい特徴があります。しかし、問題は単に換気不足だけではありません。
実は、カビの再発に深く関わっているのが “負圧現象” です。これは、室内の空気の流れが偏ることで、外の湿気や空気が壁の隙間から室内へ引き込まれてしまう状態を指します。つまり、換気がうまくいっていないだけでなく、知らない間に“湿気を引き寄せてしまっている”状態が家の中で起こっているのです。
負圧になると、壁内部に湿気が入り込みやすく、含水率が高くなり、カビが繁殖しやすくなります。この現象は目に見えないため、住んでいる人が気づくことは非常に難しく、掃除してもすぐに再発してしまう大きな原因のひとつです。
例えば、浴室の換気扇だけが強く動いている場合、家全体の空気バランスが崩れ、他の部屋に負圧が発生することがあります。またキッチンやトイレの換気扇の使い方ひとつでも、家全体の空気の動きが変わり、特定の部屋に湿気が集まることもあります。
負圧の状態を見極めるには、風量計を用いた調査が必要で、専門的な分析が欠かせません。カビの再発を防ぐには、換気を“量”ではなく“質”で考え、空気バランスを整えることが非常に重要です。
■ 室内の空気の流れの重要性
カビの発生は、湿気だけで決まるものではありません。実は “空気の流れ(気流)” がとても大きな要因として関わっています。空気がよく流れる場所では湿気がとどまりにくく、カビは育ちにくくなります。しかし、空気が動きにくい場所は湿気が溜まりやすく、カビの格好の繁殖スポットになります。
家具の裏、部屋の隅、クローゼット内部、北側の壁などは、空気の流れが極端に悪くなる場所で、関東の住宅ではこうした場所が特に多く見られます。また、気密性の高い家ほど湿気が逃げにくいため、空気の停滞が起こりやすくなります。
エアコンの位置、換気扇の配置、窓の開閉、家族の生活動線などによっても空気の流れは変わるため、住宅ごとに湿気が溜まりやすい場所は異なります。例えば、ドアを閉めたままにしている部屋は湿度がこもりやすく、空気が停滞することでカビが繁殖する可能性が高くなります。
空気の流れが悪いと、室内にいる人が気づかないまま“湿気ポケット”ができてしまい、そこにカビが広がるケースが多発しています。特に関東は天候が変わりやすく、湿度が高い日が続くことも多いため、空気の流れを意識した環境づくりが必要不可欠です。
カビ対策では、「掃除すること」よりも「空気を動かすこと」が重要な場合もあります。室内の空気の流れを改善することで、カビの発生と再発を大幅に抑えることができます。
⭐原因を突き止めるのが最重要⭐ MIST工法®カビバスターズ東京の調査内容
“カビは結果…本当の敵は原因!”見えないカビの正体を暴くための専門調査を分かりやすく解説します🕵️♂️🌱
■ 一般社団法人微生物対策協会と連携した「真菌(カビ菌)検査」
カビを根本的に解決するために重要なのが、住まいに「どの種類のカビが存在しているか」を明確にすることです。カビと言っても種類は数千以上。種類によって発生する場所、繁殖スピード、健康被害の度合い、再発しやすさなどが大きく異なります。そこでMIST工法®カビバスターズ東京では、一般社団法人微生物対策協会と連携した“真菌検査” を行い、科学的根拠に基づいてカビの種類を特定します。
真菌検査では、室内の空気中、壁の表面、埃、カビが発生している可能性のある箇所からサンプルを採取し、どんなカビがどのくらい存在しているのかを調べます。特に関東地方は湿度の高い季節が長く、エアコン内部や壁の裏側で見えないカビが大量に発生していることが多いため、この検査で“カビの正体”を知ることはとても重要です。
また、真菌検査は「まだ目に見えていない段階」でもカビが検出されることがあるため、初期段階での気づきや予防にも役立ちます。カビの種類が分かることで、どの環境で育ちやすいのか、どの部屋に影響が出やすいのか、健康リスクはどの程度かなどが具体的に理解できます。
特に、小さな子どもや高齢者、ペットのいるご家庭では、真菌検査によって“家の安全性”を知ることが安心にもつながります。カビは種類によって悪影響の強さが異なるため、原因特定の上で、この検査は非常に価値の高い調査です。
■ ファイバースコープで壁内部を確認📷
カビの大きな特徴は「見えている部分がすべてではない」ということです。むしろ、壁紙の裏・断熱材・木材の内部で広がっているケースの方が圧倒的に多く、表面の黒ずみは“氷山の一角”にすぎません。そこでMIST工法®カビバスターズ東京が行っているのが ファイバースコープ調査 です。
ファイバースコープとは、小さな穴から壁内部にカメラを入れて、中の状態を直接確認できる特殊な機器です。目では確認できない場所でも、カメラなら湿気による黒ずみ、断熱材の変色、壁内部のカビの広がりなどを詳細に観察できます。関東地方の住宅は気密性が高く温度差も大きいため、壁内部で結露が発生しカビが繁殖していることが多く、表面だけを見ただけでは判断できません。
特に、北側の壁、クローゼットの裏、寝室などは内部結露が起きやすく、壁紙をめくると一面がカビ…というケースも少なくありません。ファイバースコープ調査は、壁を大きく壊すことなく内部を確認できるため、非常に有効な判断ツールです。
“表面に出ていないカビ”を見つけることは、再発防止において最も重要なポイントです。原因が見つからなければ対策もできません。だからこそ、壁内部調査はカビ問題の根本的な解決に欠かせない重要な工程なのです。
■ 建材の含水率検査で湿気の度合いを数値化📊
カビの発生に深く関わっているのが 湿気=水分量 です。建材(木材・壁・床)がどれくらい水分を含んでいるかを調べる検査を「含水率検査」と言います。含水率とは、建材の中にどれほどの水分がとどまっているのかを示す数値で、この数値が高いほどカビが発生しやすい環境であることを示しています。
木材は含水率20%を超えるとカビが繁殖しやすくなり、内部で腐朽菌が進行する可能性もあります。しかし、含水率は見た目では分かりません。壁紙が少し浮いている、触ると冷たい、しみが出てきた…といったサインがあっても、内部の湿気の度合いは推測しかできません。そこで必要になるのが 含水率計による数値調査 です。
関東地方の住宅は結露が起きやすく、冬は内部結露、夏は湿度こもりが原因で含水率が上がる傾向があります。特に北側の寝室・クローゼット・浴室隣接の壁は含水率が高くなりやすく、測定してみると「想像以上に湿気がある」というケースが非常に多いのです。
含水率検査によって湿気の状態を“見える化”することで、
・壁内部にカビができやすい理由
・なぜ掃除しても再発するのか
・どの部分に原因が潜んでいるのか
が明確になります。
湿気の可視化は、カビの再発防止にとって非常に重要なステップです。
■ 風量計を使った負圧のチェック🌬
カビの再発に深く関係しているのが 負圧の問題 です。負圧とは、室内の気圧が外より低くなる現象で、簡単に言うと“家が外から湿った空気を吸い込んでしまう状態”です。
例えば、強力な換気扇を長時間回している家、換気バランスが崩れている家では負圧が発生しやすく、結果として壁内部に湿気が引き込まれ、カビの温床になることがあります。この状態ではどれだけ掃除しても湿気の流入が続くため、カビの再発を止めるのは困難です。
風量計を使った調査では、家の中にどれくらい空気が流れ込んでいるか、または流れ出ているかを測定し、空気の流れのバランスを科学的に確認します。関東の住宅は気密性が高い反面、換気システムの使い方や間取りの影響で負圧が起きやすく、「なぜか同じ部屋だけカビが出る」という悩みの背景には、この負圧の問題が潜んでいることが多いのです。
負圧の状態は目で見えないため、住んでいる人が気づくことはほぼ不可能です。だからこそ風量計による専門調査が必要であり、原因追究には欠かせない工程となっています。
■ 関東の家で起こりやすい“原因パターン”を紹介
カビの原因は「1つだけ」ではないことがほとんどです。関東の住宅では気候・構造・生活スタイルが重なることで、複数の原因が同時に起きているケースが非常に多いのが特徴です。
代表的な原因パターンには次のようなものがあります👇
① 北側の壁×結露×家具密着
北側の壁は冷えやすく、結露が起こり、そこに家具をピッタリつけることで湿気がこもり、カビが爆発的に増えるケース。
② エアコン内部×温度差×換気不足
冷房・暖房両方で結露が発生し、内部にカビが繁殖。換気不足でカビ胞子が室内に拡散しやすいパターン。
③ 浴室湿気×洗面所×換気不良
浴室で発生した湿気が洗面所に流れ込み、脱衣所の壁内部でカビが広がるケース。
④ クローゼット×密閉×外壁の結露
外壁側のクローゼット内部が冷えて結露し、内部でカビが繁殖。衣類にまで広がることも。
⑤ 負圧×壁内部湿気×含水率上昇
換気バランスの崩れにより湿気が壁内部に吸い込まれ、含水率が高い状態が続き再発する最も複雑なパターン。
関東の住宅は気密性が高く湿度も高いため、これらのパターンが複合的に起こりやすく、「掃除しても意味がない状態」に陥ってしまうのです。
だからこそ、真菌検査・含水率検査・負圧調査・ファイバースコープ調査などの総合的な原因追究が“再発防止のカギ”になるのです。
カビが心配な方にオススメ!真菌検査のメリットとは?
「実はこんなにすごいんです!」カビ対策の第一歩に“真菌検査”が選ばれる理由をやさしく解説🌱🔬✨
■ どんなカビがどこに発生しているか分かる
カビ問題を正確に解決するうえで最も大切なのが、「どんなカビが、どこで、どの程度発生しているのか?」 を把握することです。真菌(カビ菌)検査の最大のメリットは、この“見えない問題を見える化できること”にあります。カビは種類によって生育環境・繁殖スピード・人体への影響が大きく異なり、黒カビ・白カビ・青カビ・赤カビ(ロドトルラ)など、それぞれ性質も危険度も違います。
「壁のシミがカビなのか」「エアコンのにおいの原因が何なのか」「子ども部屋に出ている黒い点は危険なのか」「床下に広がっているのはどの種類か」……これらは目視だけでは判断できず、経験者であっても“見た目だけでは確定できない”のが現実です。
真菌検査では、専用のサンプル採取キットを使い、壁、空気中、埃、家具裏など複数のポイントから菌を採取します。そして、専門機関(一般社団法人微生物対策協会)の分析によって、どのカビが、どの程度の濃度で室内に存在しているかが明らかになります。
この検査結果が分かると、
・発生源がどこなのか
・健康リスクがある種類かどうか
・どの部屋に菌が広がっているか
・“本当に危険な場所”はどこか
などが具体的に把握できます。
つまり真菌検査は、カビ対策の“羅針盤”と言える存在。闇雲に掃除したり対策をするより、まず「正体を知る」ことで最短距離で問題解決に近づける、とても価値の高い検査なのです。
■ 再発リスクの判断にも役立つ
「掃除してもまた生えてきた…」
「カビ取り剤を使ってもすぐ戻る…」
そんな“再発ループ”には必ず理由があります。
真菌検査を行うことで、ただ「カビがある」という曖昧な状態ではなく、再発の原因がどこに潜んでいるのかが明確になります。
例えば、
・空気中にカビ胞子が多く飛んでいる → 換気の問題
・壁紙の種類のカビが優勢 → 壁内部の湿気の可能性
・エアコン由来の菌が多い → 送風経路や内部の結露問題
・家具裏の菌が強い → 空気の滞留・湿気溜まり
と、検査結果の“パターン”から再発原因を読み取ることができます。
また、カビ菌の種類によって“再発しやすいか・しにくいか”が異なります。
例えば黒カビは根が深く広がりやすく、湿度が少しでも残っていると再発しやすい性質があります。一方、赤カビのように湿った場所で一気に増えるタイプは、住まいの湿度管理が甘い時に再発が起こりやすくなります。
つまり、真菌検査によって、
・今後どれくらい再発リスクがあるのか
・どの部分を重点的に改善すべきか
・湿度・換気・空気流れの問題があるか
が分かるため、再発を防ぐための具体的な対策が行いやすくなります。
「掃除だけでは止まらない理由」を科学的に理解できるため、再発リスクを大幅に減らせるのが真菌検査の大きなメリットなのです。
■ 家族の健康管理にもプラス
真菌検査は「家を守るだけの検査」ではありません。
あなたの家族の健康を守るための検査 でもあります。
カビの種類によっては、アレルギー・ぜんそく・鼻炎・咳・皮膚トラブルなどを引き起こす可能性があり、小さな子ども・高齢者・ペットと暮らしている家庭では特に“カビと健康”の関係は無視できません。
「ただの湿気だから大丈夫」
「黒い点が少しあるけど生活に問題はないはず」
と思ってしまいがちですが、目に見えていない空気中のカビ濃度が高いケースもあります。
真菌検査で
・カビがどれくらい空気中に浮遊しているのか
・体に影響を与える可能性がある種類か
・どの部屋が危険度が高いのか
を具体的に把握することで、家族の健康管理に大きな安心を得られます。
また、アレルギー症状が出ている場合、
「もしかしてこの部屋の空気が原因かも…?」
という判断にも役立ちます。
子ども部屋や寝室、ペットがよく過ごす場所から高濃度のカビが検出されるケースもあり、検査を受けたことで家族が体調を崩していた理由に気づく方も少なくありません。
カビは“住まいの問題”であると同時に、健康問題 です。
真菌検査はその橋渡しとなる、大切なツールと言えます。
■ 引っ越し前・入居前にも有効
意外と知られていませんが、真菌検査は 「引っ越し前・入居前」にも非常に有効 です。
「新居にカビはないと思っていたのに、住んだらすぐ出てきた…」
「中古住宅を購入したら壁の裏にカビが広がっていた…」
「リフォーム済み物件なのにカビ臭い…」
こうした相談が関東ではとても多く寄せられています。
実は、見た目がキレイでも、
・壁内部の湿気
・以前の住人が放置したカビ
・エアコン内部のカビ
・床下や断熱材の湿気
など、隠れたカビの問題が潜んでいることは珍しくありません。
真菌検査を引っ越し前に行うことで、
・住んでから後悔するリスクを回避
・その住宅の“空気の安全性”を客観的に確認
・どの部屋に注意すべきかを把握
・家族が安心して暮らせる環境作り
が可能になります。
特に小さなお子様がいるご家庭、アレルギー体質の方、ペットと暮らす方は、入居前に住宅の“カビ環境”を知ることで安心感が大きく変わります。
また、賃貸契約前・売買前の判断材料としても非常に価値が高く、「知らなかった!」というトラブルを避けられる点でもメリットは大きいです。
真菌検査は、
住む前も、住んだ後も、家族と住まいを守る“心強いパートナー”となる検査なのです。
関東のカビトラブル事例
「こんなところに!?」関東ならではのカビ事情をわかりやすく紹介!実際の相談から見える“地域特有の傾向”とは🕵️♂️✨
■ 関東の気候で増えるカビの特徴
関東のカビトラブルには、他の地域とは少し違った“独特の特徴”があります。関東地方は一年を通して湿度が高く、冬は結露が多発し、夏は高温多湿という環境が続くため、カビが増える条件がそろいやすい地域として知られています。特に東京・神奈川・千葉などの沿岸部は海風の影響で湿度が高く、梅雨だけでなく春や秋でも湿気がこもりやすいのが特徴です。
また、関東の住宅は高気密化が進んでいるため、空気の入れ替えが自然に行われにくく、湿度や水蒸気が室内に残りやすい構造になっています。さらに、マンションが多い都市部では、部屋ごとの風通しのムラが生じやすく、北側の部屋や角部屋はカビのリスクが特に高まります。
関東のカビで特に目立つのは
・黒カビ(クロドスポリウム)
・エアコン内部で繁殖する黒色真菌
・洗面所やキッチンに出やすい白カビ
・梅雨〜夏に多い赤カビ(ロドトルラ)
などで、種類によって発生場所も変わります。
また、関東は気候変動の影響で豪雨や湿気の多い日が増え、秋〜冬にかけての結露トラブルが年々増加しています。結露が長時間残ることで壁紙の裏側が湿り、内部でカビが広がるケースが非常に多いのも関東ならではの現象です。
こうした“気候 × 住宅構造 × 生活スタイル”が組み合わさるのが関東の特徴で、カビが一年中発生しやすい環境が生まれています。
■ 実際に増えている相談例
関東地方では、年々カビに関する相談が増加しており、季節ごとに特徴的な相談内容があります。MIST工法®カビバスターズ東京にも、東京・神奈川・埼玉・千葉・茨城・栃木・群馬から多くの声が寄せられています。
代表的な相談例を紹介すると——
● エアコンからのカビ臭
夏前・冬前に急増する相談。
「エアコンをつけるとカビ臭い…」
「子どもがエアコンを使うと咳が出る」
という声が多く、内部の湿気や温度差が原因でカビが繁殖しているケースが目立ちます。
● 北側の寝室の黒カビ
「壁紙にうっすら黒点が…」
「ベッド裏の壁がしっとりしている」
といった相談が冬を中心に増加。結露+換気不足の典型パターンです。
● クローゼットや押入れの白カビ
梅雨〜夏に特に多い相談。
衣類・革製品・布団にカビが付着してしまうケースが増えています。
● 洗面所・脱衣所のカビ
「床がべたべたする」
「洗濯機の後ろがカビだらけだった」
など、水気の多い場所で発生しやすいトラブルが増えています。
● 新築・リフォーム後のカビ
実は近年急増しているのがこのケースです。
気密性が高い新築住宅で湿気が排出されず、建材の乾燥不足が原因でカビが出ることがあります。
● ペットや子どもの健康不調からの相談
「くしゃみが増えた」「咳が止まらない」など、健康面から発見につながる例も少なくありません。
関東の相談は“生活のあらゆる場所”から寄せられるため、相談内容が多様であることも特徴です。
■ 真菌検査から原因が分かったケース
真菌検査は「目に見えるカビ問題」を解決するだけでなく、「気づかなかった隠れた原因」を暴くことにも大きな効果があります。関東の気候と住宅構造は“隠れカビ”が非常に多く、検査によって初めて原因が見つかるケースが多発しています。
代表的な事例をご紹介します👇
● ケース①:寝室の壁紙の黒い点 → 原因は内部結露
真菌検査で壁紙裏から黒カビが検出。
含水率検査の結果、壁内部の湿度が高く、結露が原因でカビが広がっていたことが判明。
掃除では絶対に解決しない典型的なパターン。
● ケース②:エアコン使用時の咳 → 空気中の胞子濃度が高かった
検査でエアコン由来の黒色真菌が空気中に多く浮遊していることが確認され、
家族の咳・鼻炎・目のかゆみの原因になっていたケース。
● ケース③:クローゼットの白カビ → 外壁側の結露
衣類に発生した白カビの種類を特定したところ、外壁側に強く繁殖するタイプであることが分かり、
壁内部の温度差が原因で湿気が滞留していたと判明。
● ケース④:玄関の靴がすぐカビる → 家全体の負圧が原因
風量計による調査で、玄関付近が負圧状態になっていることが判明。
外から湿気が吸い込まれ、靴にもカビが増えていた事例。
● ケース⑤:赤ちゃんの寝室で咳 → ベッド裏から高濃度の菌
真菌検査により、寝室の隅や家具裏に高濃度のカビ菌があることが明らかに。
換気不足+家具密着+温度差の複合原因。
これらの事例に共通するのは
「表面だけ見ても分からない」
「掃除では絶対に根本解決しない」
という点です。
真菌検査を行うことで、
・健康被害の原因
・再発の理由
・湿気の出どころ
・空気の流れの問題
などがすべて“見える化”され、的確な対策につながります。
もう悩まない!今日からできるカビ予防テクニック✨
「プロも実践している簡単ワザ!」今日からすぐにできる“失敗しないカビ予防テクニック”をまとめてご紹介🌱✨
■ 湿度管理(50〜60%が理想)
カビの繁殖を防ぐうえで最も大切なのは、なんといっても“湿度管理”です。カビは湿度が60%を超えると一気に繁殖が活発化し、70%以上になると加速度的に広がり始めます。そのため、湿度は50〜60%を目安に保つことが理想的 です。これは毎日できる、もっとも効果的なカビ予防の方法と言えます。
湿度管理にはいくつかポイントがあります。まず必須なのが 湿度計の設置。意外にも「何となく湿っている気がする」「今日は乾燥しているはず」と“感覚”で判断してしまう方が多いのですが、湿度は思っている以上に変動しやすく、感覚では正しく判断できません。リビング・寝室・クローゼット付近など複数箇所に湿度計を置くと、正確に状況を把握できます。
関東地方は湿度が高い日が多く、梅雨〜夏だけでなく秋雨の時期も湿度が上がりやすい特徴があります。また、冬は結露が原因で局所的に湿度が高くなることもあるため、季節を問わず湿度に注意が必要です。加湿器を使う時期は特に湿度が上がりすぎていないかこまめにチェックし、60%を超えないように調整すると安心です。
湿度が高くなりがちな洗面所・脱衣所・お風呂周りは、除湿器を組み合わせることで効果が大幅に高まります。また、部屋干しをする場合はサーキュレーターやエアコンの除湿運転を活用して、空気の流れを作りながら湿度を下げるようにしましょう。
湿度をうまく管理できれば、カビの繁殖スピードは大きく抑えられます。「湿度を見る習慣」を身につけることが、今日からできる最強のカビ予防です。
■ 換気のコツとサーキュレーターの使い方
カビ予防には“空気の流れ”が欠かせません。湿気は空気の滞留する場所に溜まりやすいため、しっかり換気をして湿った空気を外へ逃がすことが大切です。関東の住宅は高気密構造が多く、空気が自然に入れ替わりにくいため、換気の工夫が特に重要になります。
まず大切なのは 「短時間×複数回の換気」。
窓を長時間開けっぱなしにするより、10分ほどの換気を数回行うほうが効率的です。部屋の対角線上にある窓を開ける「対面換気」ができると、湿気が一気に流れやすくなります。
次に、サーキュレーターの使い方がポイントです。サーキュレーターは部屋の空気を循環させる役割があり、窓に向けて風を送ることで換気効率が格段に上がります。
・窓の外に向かって風を送る → 湿気を一気に排出
・床にたまりやすい冷たい湿気を持ち上げる → 部屋全体の空気が均一に
など、工夫次第でカビ対策に大活躍します。
浴室や洗面所など湿気の多い場所は、換気扇を24時間稼働させるのが効果的ですが、換気扇が“家全体の負圧を生む原因”になることもあります。そのため、家の空気バランスを意識しながら、こまめな自然換気と組み合わせるとより安心です。
「空気が動く」だけでカビはかなり予防できます。サーキュレーターと換気をセットで使うことで、湿気はぐっとたまりにくくなります。
■ 家具配置でできるカビ対策
家具の置き方ひとつで、カビの発生リスクが大きく変わります。特に関東の住宅では、北側の壁や外壁側の部屋が結露しやすいため、家具配置には気をつける必要があります。
まず鉄則は 「家具を壁にぴったりつけない」 ことです。壁に密着させると空気が流れず、そこに湿気が溜まってしまいます。これが壁紙の裏側や家具の背面にカビが広がる原因となるため、少なくとも 5cm以上のすき間 を空けて配置するのがおすすめです。風が通るだけで湿気が逃げやすくなります。
また、ベッドやタンスなど大型家具は、北側の壁に置くと結露による湿気を吸収しやすく、カビが発生しやすくなります。可能であれば、南側や風通しの良い場所に配置を変えるとリスクがぐっと減ります。どうしても北側に置く場合は、数ヶ月に1度は家具を少し動かし、カビや湿気のチェックをする習慣をつけましょう。
クローゼット内部も同様で、ぎっしり詰めこまれた衣類は空気が通らず湿気の温床になります。
・衣類は7割収納を意識
・下段に物を積み上げすぎない
・スノコを敷いて風を通す
などの工夫が効果的です。
家具配置は「見えない湿気をどう逃がすか」を考えるのがポイント。今日からできる簡単な見直しだけで、カビの発生率は大幅に下がります。
■ 季節ごとの注意点(梅雨・冬・秋雨など)
季節によってカビが発生する理由は異なります。関東地方の気候は季節ごとの差が大きく、季節ごとの対策がとても重要です。
🌧梅雨(6〜7月)
湿度80%を超える日が多く、家中がカビの繁殖条件を満たしやすい季節です。特に
・北側の寝室
・クローゼット
・浴室・洗面所
は要注意。除湿器やエアコンの除湿運転を活用し、湿度を50〜60%に保つことが必須です。
☀夏(7〜9月)
高温多湿でカビが一気に成長する時期です。エアコン内部は結露が発生しやすく、冷房を停止した後に湿気が残るため、送風モードを使って内部を乾かすのが効果的です。部屋干しも湿気の原因になるため、サーキュレーター併用が必須です。
🍂秋(秋雨前線の時期)
意外とカビが増える時期。湿度が高く、気温が下がらないため、夏と同じようなカビ環境が続きます。衣替えの際はクローゼットの湿気チェックが大切です。
❄冬(12〜2月)
室内外の温度差が大きく、結露が最も発生する季節。北側の壁、窓際、家具裏は特に注意が必要です。加湿器の使いすぎにも要注意で、湿度60%以上になる場合は調整が必要です。
季節に合わせた対策をすることで、カビの発生を大幅に減らすことができます。「季節×湿気×空気の流れ」を意識することが、関東の住宅では特に重要なのです。
【まとめ】手に負えないカビは原因追究が必須!関東のカビ対策は私たちにお任せください💪🌱
「あなたの家は、もっと安心できる場所へ。」カビに悩まない暮らしを取り戻すための総まとめ🌱💪✨
■ 再発防止は“原因の見える化”がカギ
カビ問題を本当に解決するためには、ただ掃除をするだけでは不十分です。
最も大切なのは、“原因がどこにあるのかを見える化すること”。
関東地方の住宅は、高気密・高断熱で湿気がこもりやすく、壁の中や建材の内部で結露が起きやすいため、カビが「見えない場所」で広がっているケースが非常に多くあります。「掃除したのにまた生えてきた…」「市販のカビ取り剤を使ってもすぐ戻る…」という悩みは、この“隠れた原因”が取り除けていないから起こるのです。
表面だけを見て判断すると、根本原因が放置されたままになるため、何度でも再発してしまいます。カビをなくすための最も効果的な第一歩は、
・どの種類のカビが
・どこに、どれくらい
・どんな環境で
発生しているかを正しく知ること。
原因を特定することで、
・どんな対策が必要か
・何を改善すべきか
・再発の可能性はどれくらいか
がはっきり分かり、無駄な対策をしなくてすみます。
カビ問題は「見えないからこそ、怖い」。
だからこそ“原因の見える化”が絶対に欠かせないのです。
悩みを繰り返さないためにも、原因の特定こそが最大のカビ予防策になります。
■ カビバスターズ東京が関東の住まいを全力サポート
MIST工法®カビバスターズ東京は、関東の住宅事情を熟知したカビ対策の専門スタッフがそろっています。東京・神奈川・千葉・埼玉・茨城・栃木・群馬まで、関東一円の“カビトラブル”に対応。地域の気候・住宅構造・生活スタイルを理解したうえで、最適な調査とアドバイスを行っています。
カビの悩みは、生活の質を大きく下げてしまいます。
・部屋がカビ臭い
・家族の咳が止まらない
・洗面所や寝室が湿っぽい
・壁紙に黒い点々が増えている
・エアコンをつけるとにおいがする
こうした状態が続くと、ストレスはもちろん、健康リスクにもつながります。
カビバスターズ東京では、“表面的な掃除”ではなく“原因そのもの”を探り、どうしてそこにカビが生えたのか、どうすれば再発しないのかを科学的に分析します。関東の住宅に多い「壁内部の湿気」「負圧による湿気吸引」「エアコン内部の温度差」「北側の結露問題」など、一般のご家庭では気づけない部分まで徹底的に調査します。
「もうカビで悩みたくない」
「家族が安心して暮らせる環境にしたい」
そんな思いに、私たちは全力で寄り添います。
■ 真菌検査・含水率検査のご案内
カビ対策の出発点として、真菌検査と含水率検査 は非常に重要です。
これらの検査は、目では見えないカビの状態を正確に把握できる“住まいの健康診断”です。
🔬 真菌(カビ菌)検査では
・どの種類のカビが
・どの程度の濃度で
・どの場所に存在しているか
を専門機関(一般社団法人微生物対策協会)で科学的に分析します。
カビの種類ごとに、
・どんな環境で増えるのか
・健康リスクはどれくらいか
・再発しやすいか
なども異なるため、真菌検査は“カビ問題の根本原因”を知るための最重要ポイントです。
📊 含水率検査では
・壁や木材にどれくらい湿気が溜まっているのか
・内部結露が起きているのか
・カビの繁殖リスクがどれほど高いか
を数値で判断できます。
関東地方では、冬の結露や夏の湿気こもりにより、内部の湿度が高くなりやすく、含水率が高いまま放置されている家がとても多いのです。含水率が20%を超えると木材内部でカビが繁殖しやすくなり、表面掃除だけでは解決が難しくなります。
これらの検査を行うことで、カビの発生源と環境要因が明確になり、適切な改善策につながります。
「まずは現状を知りたい」という方にも安心して受けていただける調査です。
■ お問い合わせ・相談ページへの誘導
カビ問題は「少し気になる」段階で相談するのが一番のポイントです。見た目では軽いと思っていても、内部ではカビが進行しているケースが関東ではとても多く見られます。
もし今、
・カビ臭が気になる
・家族の咳やアレルギーが増えた
・壁紙に小さなシミが出てきた
・エアコンからにおいがする
・床や家具裏がしっとりしている
…そんなサインがあるなら、早めにご相談ください。
MIST工法®カビバスターズ東京では、
📩 公式お問い合わせフォーム
📱 LINEで写真を送るだけの簡単相談
📞 お電話でのご相談
など、どのような方法でも気軽に相談できる環境を用意しています。
「こんな小さなカビでも相談していいのかな…?」
もちろん大丈夫です✨
むしろ、早い段階でのご相談は カビの拡大を防ぐ最大のチャンス です。
関東で起こるカビの悩みは、私たちがしっかりサポートします。
どうぞお気軽にお問い合わせください🌱💚
■カビ検査・カビ調査・カビ取り・除菌などカビの事なら何でもお任せください■
-------カビ対策専門のカビバスターズ東京---------
対応エリア:東京・神奈川・千葉・埼玉・栃木・群馬・山梨・静岡・長野
お客様専用フリーダイヤル:0120-767-899
TEL:050-5527-9895 FAX:050-3131-0218
株式会社ワールド|カビバスターズ東京
【本社】〒152-0004 東京都目黒区鷹番1丁目1-5 フラットフォー本社ビル4F
【世田谷営業所】〒157-0067 東京都世田谷区喜多見2丁目5-1 PenthouseTB2F